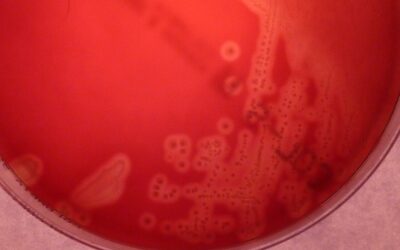
Abuso de antibióticos na pandemia quase quadruplica índice de resistência de bactéria perigosa para bebês

A colunista de meio ambiente comenta filme ‘Últimas palavras com Dra. Jane Goodall’
quadrinhos
Colunistas

Luiza Moura
Bacharela em relações internacionais na PUC-SP e ativista socioambiental.

Thaciana de Sousa Santos
Tatá, é estudante de graduação do Instituto de Física da Universidade de São Paulo e escreve semanalmente para o Ciência na Rua.

Vinicius Almeida
Vinne, é estudante de ciências econômicas na Escola Superior de Agricultura Luiz de Queiroz (Esalq-USP).
Acompanhe nas redes
ASSINE NOSSO BOLETIM
Debates
Publicações anteriores
Podcasts
publicidade
Instituto Ciência na Rua
Apoiadores